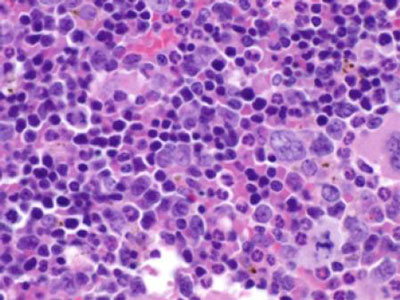

干细胞的“监护人”:miR-146a
来源:生物360
当机体发生感染时,血液中的干细胞会立即采取行动,增殖并分化为成熟的免疫细胞,与疾病展开斗争。但反复感染和慢性炎症会使这些干细胞耗竭,从而引起严重的血液疾病,例如癌症。现在,科学家们发现一种 RNA 分子能够在炎症中为干细胞提供保护。
MicroRNA-146a 是炎症中的一个关键负调节子。加州理工学院(Caltech)的研究团队在小鼠模型中发现, microRNA-146a(miR-146a)还在慢性炎症中充当了造血干细胞(HSC)的保护者。他们提出,miR-146a 缺乏是血癌等疾病的一个重要致病因素。
MicroRNA 是能够干涉或调解特定基因活性的小 RNA。研究团队建立了 miR-146a 缺陷型小鼠模型,他们发现当这些小鼠处于慢性炎症状态时,造血干细胞的总数减少质量降低。而对照组的正常小鼠,能够在长时期炎症中更好的维持造血干细胞水 平。文章于五月二十一日发表在《eLIFE》杂志上。
研究人员表示,miR-146a 缺陷型小鼠是非常好的研究模型,可以帮助人们理解慢性炎症引起的肿瘤形成,以及慢性炎症对造血干细胞产生的影响。单个 microRNA 扮演着如此重要的角色,这令我们感到惊讶。miR-146a 维持着造血干细胞的质量和寿命,研究显示,去除这一分子会对造血干细胞产生深远而剧烈的影响,说明miR-146a守护造血干细胞的功能不可或缺。”
这项研究首次展现了慢性炎症与血液疾病之间的详细分子关联。这些发现将帮助人们开发新的抗炎症分子,并将其用于治疗相关血液疾病。实际上,研究人员认为 miR-146a 就有望成为非常有效的抗炎症分子,只要能够将它(或类似物)更有效的运送到目标细胞。
这一小鼠模型也模拟了人类骨髓增生异常综合症MDS的许多重要方面。这种疾病会引起严重的贫血,往往需要频繁输血,此外 MDS 还容易引发急性髓系白血病。研究人员指出,利用这一模型进行深入研究,将帮助人们更好的理解相关疾病,为 MDS 开发出新的治疗药物。
这项研究体现了控制慢性炎症的重要性,再次强调了广泛使用抗炎症分子的意义,如果研究人员能够在慢性炎症引发的肿瘤形成和干细胞耗竭中,明确最为重要的细胞类型和蛋白,就有望开发出更安全有效的药物来进行干预。
原文检索:
Jimmy L Zhao, Dinesh S Rao, Ryan M O' Connell, Yvette Garcia-Flores, David Baltimore. MicroRNA-146a acts as a guardian of the quality and longevity of hematopoietic stem cells in mice. eLife May 21, 2013; DOI: 10.7554/eLife.00537

